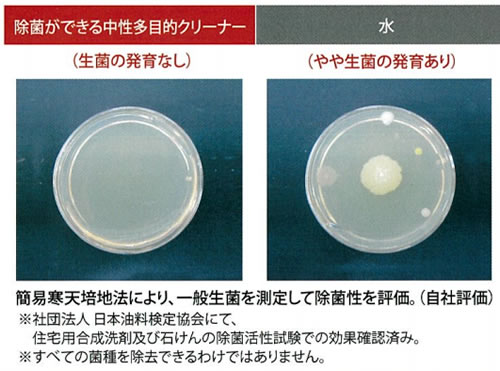

|
|
■包装資材 ■包装機械 ■物流機器 ■測定機器 ■洗剤 ■ケミカル ■蛍光灯 ■季節品-夏 ■季節品-冬 ■弱電工具 ■ホイスト ■環境機器 ■掃除機 ■ムーブテック ■切削工具 ■機械工具■調理厨房機器 ■研究室用品 ■安全防犯防災品 ■エクステリア ■新商品 ■在庫処分

| コロナ対策除菌中性多目的クリーナー/ 品番 M2994PEA-504S | 【詳細表示】 | |
| 商品番号 | M2994PEA-504S | 価 格 |
 |
新型コロナウィルスに有効な界面活性剤を配合! 除菌ができる中性多目的クリーナー 除菌と洗浄と消臭が同時にできるトリプル効果! 工場・オフィス・住居内等、どこでも手軽に使える 希釈の手間がかからずそのまま使える原液タイプ |
コロナ対策除菌中性多目的クリーナー 品番 M2994PEA-504S |
| ■新型コロナウイルスに有効な界面活性剤ポリオキシエチレンアルキルエーテルを配合! ●除菌ができる中性多目的クリーナー ■手指がよく触れる場所を清潔にしましょう! 洗浄個所に適量塗布し、きれいなタオルなどで拭き上げます。 洗剤塗布にハンドスプレーを使用すると便利です。  ※水が浸み込む材質(無垢材、革製品など)、ABS樹脂にはご使用いただけません。 ※電話機、キーボード、リモコンなど、スイッチまわりに使用する時は内部に洗剤が入らないようにご注意ください。 ■洗浄性試験  ■除菌性試験 ■環境対応 ●環境ホルモン対応 環境省「内分泌攪乱作用を有すると疑われる化学物質(67物質)」を原料として使用しておりません。 ●シックハウス(スクール)に配慮 シックハウス(スクール)の原因にあげられた「厚生労働省指針値該当成分(13物質)」については、これらを原料として使用しておりません。 ●PRTR法対応 PRTR法に該当しておりません。 |
||
運賃、および消費税は、記載価格には、含まれていません。

[トップページに戻る] [注文書] [見積り依頼] TEL 0729-64-8663 FAX 0729-61-4874
営業時間 AM9:00~PM7:00 営業日 月曜日~金曜日 定休日 土曜日 日曜日 祝日